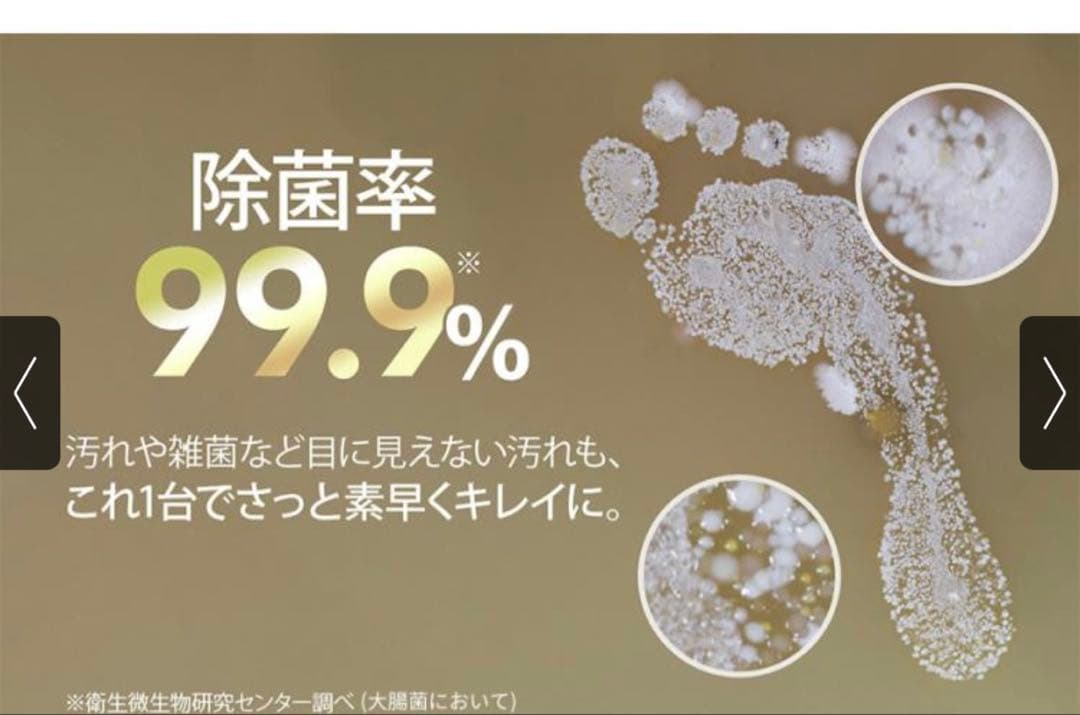
ミンドーアクアエックス　MIA-N001 CRM 未開封

福袋 オンライン ミンドーアクアエックス MIA-N001 CRM 未開封 掃除機・クリーナー
(4590件)
Pontaパス特典
サンキュー配送
14822円(税込)
149ポイント(1%)
Pontaパス会員ならさらに+1%ポイント還元!
送料
(
)
4582
配送情報
お届け予定日:2026.04.11 12:36までにお届け
※一部地域・離島につきましては、表示のお届け予定日期間内にお届けできない場合があります。
ロットナンバー
68167228095
お買い物の前にチェック!

Pontaパス会員なら
ポイント+1%
ポイント+1%
商品説明
ミンドー アクアエックス水拭き掃除機 MIA-N001 CRM2025年3月29日に購入しました。高圧洗浄機 コードレス 6in1 多機能 マルチノズル 軽量 ケース付き 掃除機。未開封新品です。ルンバ 960。購入時の領収書をお付けします。美品 HITACHI 日立 クリーナー用パワーヘッド D-AP32。購入日より1年間のメーカー保証付き購入価格:34010円お色:クリーム★未開封品に付き購入後のクレームは対応しかねますのでしっかりとご理解いした上でのご購入をお願いします。マキタ掃除機 18V充電クリーナー コードレス カプセル掃除機式 新品。丁寧なお取引きを心掛けております♡重複しているディズニーグッズや美品のお洋服を順次出品しております。Kyvol E31 ロボット掃除機。是非覗いてみてください↓↓↓#ibuiburinのディズニーグッズ セール SALE!#ibuiburinのダッフィーグッズ セール SALE!| カテゴリー: | 生活家電・空調>>>スティッククリーナー>>>スティッククリーナー本体 |
|---|---|
| 商品の状態: | 新品、未使用","新品で購入し、一度も使用していない |
| ブランド: | Aqua-X |
| 配送料の負担: | 送料込み(出品者負担) |
| 配送の方法: | 佐川急便/日本郵便 |
| 発送元の地域: | 埼玉県 |
| 発送までの日数: | 1~2日で発送 |
レビュー
商品の評価:




 4.4点(4590件)
4.4点(4590件)
- まあしい3211
- ダイソンV8にぴったりで助かりました。 ただちょっとお値段が高いと感じました。
- t-tc
- 壁に穴を開けたくなかったので、購入しました。場所も取らないのでスマートに収納出来て良かったです。
- 横浜頑張郎
- 床に置きっぱなしだったダイソンがやっとスタンドに収まりました。スタイリッシュで組み立ても簡単でした。
- masakun_ymg
- ダイソン用に購入しました 安定感バッチリです 買って良かったです
- Pe.angel
- 壁に穴を開けることなく、オシャレにダイソンクリーナーを収納できました。 ただ、ウチのダイソンは対応品では無かったみたいで、多少ブラケットを加工しての取り付けになりました。
- ちぃず9歳
- 購入後すぐ届きました。 組み立ても簡単ですぐ使えます。グラつきもなくコンパクトに収納できて満足しています。 電源ケーブルをすっきり見せるためにケーブルクリップのようなものが付属していればさらに良かったと思いました。 購入前からわかっていたことですが、アタッチメントが1つ収納できなかったことはやはり残念ですが、多分使わないものもあるのであまり実用性に影響はないと思われます。
- CYACO1204
- 初めてダイソンのコードレス掃除機を買うのに合わせてこちらを購入しました。付属のパーツなどもスッキリと収納でき、圧迫感もない高さで気に入りました。
- l i l y
- スタイルがすっきりしててダイソンがスマートに収納できました。
- Mas417a
- 組み立ては、女ひとりで、約2時間、部品が多く、組み立て順に注意を払いながら、ゆっくりしました。 工具は、プラスドライバーだけでよいですが、木ダボを入れるのに、金づちがあれば便利ですね。 部分的に、ビスが固いので、電動ドライバーも利用しました。 このたび、ホワイトダイソンを購入したので、スタンドもリビングの壁に合わせて、ホワイトを選びました。すっきりと収納できたので、まずまず満足♪ 掃除機は、毎日数回、取り外しをするので、スタンドの耐久性がちょっと心配です。 他のタイプのスタンドも、色々ありますが、安定感のある、こちらでよかったです☆彡
- mt-trg
- ダイソンのコードレス掃除機V8を購入して 付属ツールと本体がどうにかまとまらないものかな?と悩んでいたら この商品が気になり レビューを参考にに購入しました。 掃除機と付属ツールがスッキリして 見た目もちょっと洒落ていて 気に入ってます。 掃除機スタンドも しっかりしていて良い物だと思います。 ショップも迅速な対応で助かりました。
すべて見る
お店の情報
7,367
連絡・応対
4.3
配送スピード
4.3
梱包
4.3